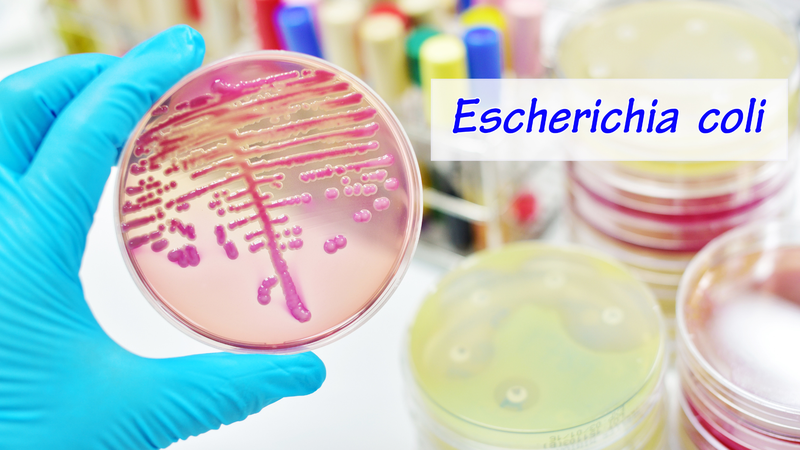
Viêm bàng quang cấp: Nguyên nhân, triệu chứng, điều trị và phòng ngừa 2

Tốt nghiệp chương trình Sau Đại học Chuyên khoa I Nhi khoa tại Đại học Y Hà Nội. Bác sĩ có hơn 15 năm kinh nghiệm trong lĩnh vực khám và điều trị các bệnh lý Nhi khoa.
:format(webp)/viem_bang_quang_cap_nguyen_nhan_trieu_chung_dieu_tri_va_phong_ngua_8_890e7dc9aa.png)
:format(webp)/viem_bang_quang_cap_nguyen_nhan_trieu_chung_dieu_tri_va_phong_ngua_8_890e7dc9aa.png)
Bác sĩ Chuyên khoa 1Nguyễn Thị Hương Lan
Tốt nghiệp chương trình Sau Đại học Chuyên khoa I Nhi khoa tại Đại học Y Hà Nội. Bác sĩ có hơn 15 năm kinh nghiệm trong lĩnh vực khám và điều trị các bệnh lý Nhi khoa.
Viêm bàng quang cấp là tình trạng nhiễm trùng tiểu dưới phổ biến, đặc biệt là ở phụ nữ. Khoảng 40 - 60% phụ nữ sẽ mắc nhiễm trùng tiểu vào một thời điểm nào đó trong đời. Mặc dù thường được điều trị ngoại trú, nhưng mức độ nghiêm trọng của bệnh có thể khác nhau ở mỗi người và cần phải có chiến lược điều trị phù hợp.
Nhiễm trùng tiết niệu có thể ảnh hưởng đến một hoặc nhiều bộ phận của đường tiết niệu nhưng phổ biến nhất là nhiễm trùng bàng quang (viêm bàng quang). Nhiễm trùng cấp tính khi bệnh khởi phát đột ngột và triệu chứng phát triển nhanh chóng.
Nhiễm trùng tiết niệu là bệnh lý nhiễm trùng phổ biến xảy ra khi vi khuẩn, thường từ da hoặc trực tràng, xâm nhập vào niệu đạo và gây nhiễm trùng đường tiết niệu. Hệ tiết niệu bao gồm thận, niệu quản, bàng quang và niệu đạo. Nhiễm trùng thận (viêm đài bể thận) ít phổ biến hơn nhiễm trùng bàng quang (viêm bàng quang) nhưng nghiêm trọng hơn.
Khoảng 40% đến 60% phụ nữ bị nhiễm trùng tiết niệu vào một thời điểm nào đó trong đời, trong đó ½ là ở độ tuổi 32. Sự gia tăng của căn bệnh này dẫn đến 8 triệu lượt khám, 100.000 lượt nhập viện và 3,5 tỷ USD chi phí chăm sóc sức khỏe hàng năm ở Hoa Kỳ. Có khoảng 27 - 46% phụ nữ sẽ bị nhiễm trùng tiểu tái nhiễm hoặc tái phát trong vòng một năm kể từ lần nhiễm trùng tiểu trước đó. Ước tính có khoảng 30% - 44% phụ nữ sẽ bị nhiễm trùng tiểu lần thứ hai trong vòng 6 tháng kể từ lần nhiễm trùng tiểu đầu tiên.
:format(webp)/viem_bang_quang_cap_nguyen_nhan_trieu_chung_dieu_tri_va_phong_ngua_10_a0f830419c.png)
:format(webp)/viem_bang_quang_cap_nguyen_nhan_trieu_chung_dieu_tri_va_phong_ngua_9_2163a240c0.png)
:format(webp)/viem_bang_quang_cap_nguyen_nhan_trieu_chung_dieu_tri_va_phong_ngua_8_890e7dc9aa.png)
:format(webp)/viem_bang_quang_cap_nguyen_nhan_trieu_chung_dieu_tri_va_phong_ngua_10_a0f830419c.png)
:format(webp)/viem_bang_quang_cap_nguyen_nhan_trieu_chung_dieu_tri_va_phong_ngua_9_2163a240c0.png)
:format(webp)/viem_bang_quang_cap_nguyen_nhan_trieu_chung_dieu_tri_va_phong_ngua_8_890e7dc9aa.png)
Các triệu chứng của viêm bàng quang cấp tính điển hình bao gồm:

Nếu tình trạng viêm bàng quang cấp không được chẩn đoán và điều trị sớm, bệnh lý này có thể phát triển nghiêm trọng và gây những biến chứng, bao gồm:
Nếu bạn có các triệu chứng của viêm bàng quang cấp hoặc bạn là đối tượng dễ có biến chứng của bệnh như phụ nữ có thai, cần lập tức đến các cơ sở y tế uy tín để được thăm khám và điều trị kịp thời. Nếu bạn đang trong quá trình điều trị và các triệu chứng của bạn không chấm dứt trong một tuần, bạn hãy đến tái khám và có thể sẽ được bác sĩ thay đổi loại kháng sinh khác.
Nguyên nhân chính gây viêm bàng quang cấp là vi khuẩn. Loại vi khuẩn phổ biến nhất gây viêm bàng quang cấp là Escherichia coli - loại vi khuẩn gây ra khoảng 80% trường hợp viêm bàng quang cấp.
Một số loại vi khuẩn khác gây bệnh như: Proteus mirabilis, Klebsiella, Staphylococcus saprophyticus, Pseudomonas aeruginosa,... Những vi trùng này xâm nhập vào niệu đạo và sau đó là bàng quang dẫn đến nhiễm trùng bàng quang.
Vi khuẩn xâm nhập vào bàng quang, tấn công vào lớp niêm mạc và dưới niêm mạc, phá hủy hàng rào bảo vệ của bàng quang, bám dính, nhân lên và tiết ra các độc tố. Khi bị tổn thương, bàng quang trở nên nhạy cảm hơn và gây ra các triệu chứng của bệnh như đau hạ vị, tiểu gắt, tiểu lắt nhắt, tiểu gấp.
Viêm bàng quang cấp cũng có thể không do nhiễm khuẩn. Một số bệnh lý hoặc điều trị của bệnh khác cũng có thể làm miễn dịch cơ thể bị suy giảm và ảnh hưởng đến hàng rào bảo vệ của bàng quang như:
Nhịn tiểu thường xuyên, uống không đủ nước, vệ sinh vùng kín kém, sử dụng sản phẩm có hóa chất mạnh và mặc đồ lót quá chật là những thói quen xấu dễ gây viêm bàng quang cấp.
Viêm bàng quang cấp gây ra tiểu buốt, tiểu rắt, đau tức vùng bụng dưới và cảm giác khó chịu liên tục. Những triệu chứng này làm gián đoạn sinh hoạt hàng ngày, giảm hiệu suất làm việc và ảnh hưởng đến giấc ngủ. Nếu không điều trị đúng cách, bệnh có thể tiến triển thành nhiễm trùng thận.
Nếu không điều trị đúng cách, nhiễm trùng có thể lan lên thận, gây viêm bể thận và suy thận. Biến chứng khác bao gồm tiểu ra máu kéo dài và nhiễm trùng huyết, đe dọa tính mạng người bệnh.
Nguyên nhân phổ biến nhất là do vi khuẩn E. coli xâm nhập vào đường tiết niệu. Ngoài ra, thói quen nhịn tiểu lâu, vệ sinh vùng kín không đúng cách, sử dụng các sản phẩm có chất tẩy mạnh hoặc quan hệ tình dục không an toàn cũng có thể làm tăng nguy cơ mắc bệnh.
Do cấu tạo niệu đạo của phụ nữ ngắn và gần hậu môn, vi khuẩn dễ dàng xâm nhập vào bàng quang. Thêm vào đó, hoạt động tình dục, thay đổi nội tiết tố và vệ sinh không đúng cách cũng làm tăng nguy cơ nhiễm trùng đường tiết niệu.
Hỏi đáp (0 bình luận)